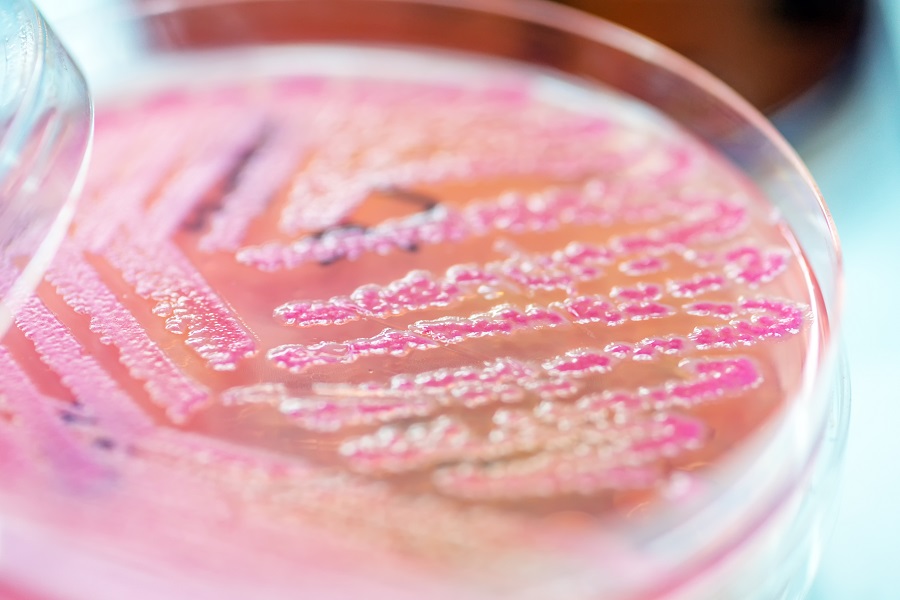
Nahaufnahme einer Bakterienkultur

Die Bekämpfung von Infektionskrankheiten ist weiterhin eine große Herausforderung. Das „Global Antibiotic Research and Development Partnership“ (GARDP) hat es sich zum Ziel gemacht, neue Antibiotika zu entwickeln und für Patienten weltweit zugänglich zu machen.
GARDP verfolgt das Ziel, einen nachhaltigen, gerechten und erschwinglichen Zugang zu neu entwickelten Antibiotika zu gewährleisten.
Adobe Stock / analysis121980
Dr. iur. Peter Beyer ist Jurist und hat mehr als 12 Jahre für die Weltgesundheitsorganisation gearbeitet.
Herr Dr. Beyer, was ist eine Sepsis?
Eine Sepsis ist ein lebensbedrohlicher Zustand, der auftritt, wenn die extreme Reaktion des eigenen Körpers auf eine Infektion zu einer weit verbreiteten Entzündungsreaktion und Organfehlfunktion führt. In einigen Fällen entstehen Organ- und Gewebeschäden. Aufgrund einer Sepsis kann sich ein septischer Schock, multiples Organversagen und der Tod einstellen, insbesondere, wenn sie nicht rechtzeitig erkannt und behandelt wird.
Jedes Jahr erkranken weltweit 20 bis 30 Millionen Patientinnen und Patienten an einer Sepsis. Was sind die Gründe für die hohe Zahl der Fälle?
Eine Sepsis kann durch bakterielle Infektionen, Pilzinfektionen und virale Infektionen ausgelöst werden. Es gibt unterschiedliche Faktoren, die weltweit zu einem Anstieg der Sepsisfälle beitragen:
Welche Präventionsstrategien wurden bisher eingesetzt, um die Häufigkeit von Sepsen zu verringern?
Hierbei ist die Öffentlichkeitsarbeit ein sehr wichtiger Faktor. Kampagnen zur Sensibilisierung der Öffentlichkeit für gute Hygiene (z. B. Händewaschen und erste Hilfe bei kleineren Verletzungen), verbesserte sanitäre Einrichtungen und Wasserqualität sowie Impfprogramme tragen dazu bei, die Ausbreitung von Infektionen und die Resistenz gegen antimikrobielle Mittel in der Bevölkerung zu verhindern. Die Inanspruchnahme von Routinebehandlungen bei chronischen Erkrankungen und die Reduzierung des unangemessenen Antibiotikaverbrauchs sind ebenfalls gute Präventionsstrategien. In der Gesundheitsfürsorge werden mehrere Strategien zur Verringerung der Sepsisinzidenz angenommen. Hierunter fallen die Aufklärung zur Sensibilisierung und zum besseren Verständnis der Sepsis, der rechtzeitige Zugang zu medizinischen Leistungen, der rationale und verantwortungsbewusste Einsatz von Antibiotika (engl. „Antibiotic Stewardship“), die Infektionskontrolle, einschließlich einer wirksamen persönlichen Schutzausrüstung, sowie auch die Erforschung neuer und erschwinglicher Diagnosetechnologien.
Die Global Antibiotic Research and Development Partnership (GARDP) ist eine gemeinnützige Organisation, die 2016 von der Weltgesundheitsorganisation (WHO) und der Initiative "Drugs for Neglected Diseases" (DNDi) zur Erforschung und Entwicklung neuer Antibiotika gegründet wurde. Können Sie uns einen Überblick über die Forschungsaktivitäten geben, insbesondere im Hinblick auf die Sepsis?
Gemeinsam mit Partnern setzt sich GARDP dafür ein, dass mehrere Sepsis-Therapien entwickelt und zugänglich gemacht werden, darunter das Antibiotikum Cefiderocol (welches 2020 von der Europäischen Arzneimittelagentur zugelassen wurde) und das Kombinationspräparat Cefepime-Taniborbactam (dessen Zulassung von der US Food and Drug Administration geprüft wird).
Neben der Entwicklung potenzieller Behandlungsmöglichkeiten für Erwachsene arbeiten wir an Antibiotika für Kinder, wobei der Schwerpunkt auf der neonatalen Sepsis liegt. 1 von 5 Todesfällen im Zusammenhang mit antibiotikaresistenten Infektionen tritt weltweit bei Kindern unter fünf Jahren auf. Wir führen derzeit eine globale Studie durch, um die Sicherheit und Wirksamkeit von Antibiotika-Kombinationstherapien als neue Alternativen für die Behandlung der neonatalen Sepsis zu untersuchen.
Eine weitere Sorge von GARDP ist die Zunahme der Zahl der sexuell übertragbaren Infektionen, insbesondere die Verbreitung von arzneimittelresistenter Gonorrhöe, gegen die wir ebenfalls neue Behandlungsmöglichkeiten entwickeln.

Dr. iur. Peter Beyer
S. Deshapriya
Gibt es bestimmte bakterielle Erreger, die im Zusammenhang mit einer Sepsis besonders problematisch sind?
Die Sepsis ist nicht erregerspezifisch. Schwere Krankenhausinfektionen (engl. hospital-acquired infections (HAI)) sind jedoch in der Regel schwerwiegender und führen häufig zu einer Sepsis, was zu einer hohen Morbidität und Mortalität führt. Die für HAI verantwortlichen Erreger sind häufig gegen einige oder alle verfügbaren Antibiotika der ersten Wahl resistent. Derzeit sind die am schwierigsten zu behandelnden HAI diejenigen, die durch Carbapenem-resistente gramnegative Erreger verursacht werden, insbesondere Enterobacterales, Pseudomonas-Arten und Acinetobacter-Arten. Die meisten grampositiven HAI sind auf Staphylococcus-Arten zurückzuführen, insbesondere auf Methicillin-resistente Staphylococcus aureus (MRSA).
Welche anderen Ziele verfolgt die GARDP?
GARDP ist weltweit die einzige Organisation, die Forschung, Wissenschaft und akademische Gemeinschaften mit der notwendigen Expertise zusammenbringt, um die Ausbreitung von Antimikrobiellen Resistenzen (AMR) zu bekämpfen – keine andere Organisation tut dies so umfassend auf globaler Ebene.
Unsere REVIVE-Plattform bietet Webinare, eine antimikrobielle Enzyklopädie, von AMR-Experten verfasste Stellungnahmen und andere frei zugängliche Instrumente für alle Forschenden dieses Bereichs. Die REVIVE-Webinarreihe ist einzigartig, da sie sich auf die Vermittlung von aktuellem Fachwissen über antimikrobielle Forschung und Entwicklung konzentriert.
GARDP betreibt auch Forschung zur Entdeckung neuartiger Substanzen, die das Potenzial haben, entweder zu einem neuen Antibiotikum entwickelt zu werden oder die Aktivität eines bestehenden Antibiotikums wiederherzustellen, welche durch Arzneimittelresistenz beeinträchtigt wurde. Wenn diese identifizierten Substanzen in unsere Strategie passen, nehmen wir sie in unser Portfolio auf. Wenn sie nicht in unsere Strategie passen, teilen wir sie mit der Öffentlichkeit, damit wiederum andere die Möglichkeit haben sie entwickeln zu können.